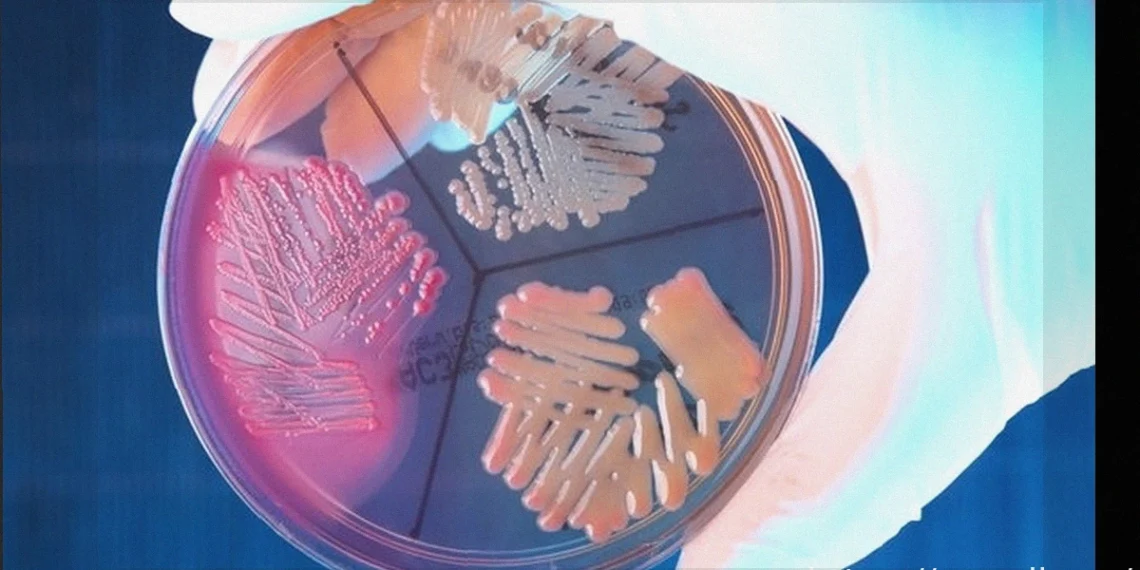

Стафилококки — это грамположительные бактерии округлой формы, которые часто собираются в группы, напоминающие гроздь винограда. Эти микроорганизмы могут естественным образом обитать на коже и слизистых оболочках человека, не вызывая при этом каких-либо заболеваний.
Однако в ситуациях, когда иммунная система ослаблена (например, у новорожденных, пациентов после химиотерапии или пожилых людей) или недостаточно развита, бактерии рода Staphylococcus способны проникнуть в организм и спровоцировать развитие болезни.
Основными клинически значимыми видами стафилококков являются Staphylococcus aureus, Staphylococcus epidermidis и Staphylococcus saprophyticus. Для назначения наиболее эффективного лечения крайне важно, чтобы врач точно определил конкретный вид бактерии и её чувствительность к препаратам.
Основные виды стафилококков и связанные с ними заболевания:
1. Staphylococcus aureus (Золотистый стафилококк)
Staphylococcus aureus, или S. aureus, часто обнаруживается на коже и слизистых оболочках, особенно в полости рта и носа, у здоровых людей, не вызывая при этом инфекций.
Тем не менее, при ослаблении защитных сил организма S. aureus может проникнуть в ткани и вызвать инфекции различной степени тяжести — от лёгких кожных воспалений, таких как фолликулит, до серьёзных, угрожающих жизни состояний, например, сепсиса.
Золотистый стафилококк может попасть в организм через повреждения кожи (раны) или инъекционные процедуры, особенно у госпитализированных пациентов, людей, употребляющих инъекционные наркотики, или тех, кто регулярно получает инъекции. Передача бактерии также возможна от человека к человеку при прямом контакте или через респираторные капли, выделяемые при кашле и чихании.
Основные симптомы: Симптоматика инфекции, вызванной S. aureus, варьируется в зависимости от локализации процесса, пути заражения и общего состояния организма. При кожной инфекции могут наблюдаться боль, покраснение и отёк. При проникновении бактерии в кровь могут развиться системные симптомы: высокая температура, мышечная и головная боль, а также общее недомогание.
Как проводится лечение: Лечение инфекции Staphylococcus aureus подбирается индивидуально, основываясь на профиле чувствительности бактерии к антимикробным препаратам, который может различаться у разных пациентов и в разных медицинских учреждениях. Врач также учитывает общее состояние здоровья пациента, характер проявляющихся симптомов и наличие других сопутствующих инфекций. Обычно назначают антибиотики, такие как Метициллин, Ванкомицин или Оксациллин, курсом от 7 до 10 дней.
2. Staphylococcus epidermidis (Эпидермальный стафилококк)
Staphylococcus epidermidis, или S. epidermidis, является обычным обитателем кожи человека и в норме не вызывает каких-либо инфекций. Однако S. epidermidis считается условно-патогенным микроорганизмом, способным вызвать заболевание при ослаблении или незрелости иммунной системы, например, у новорожденных.
S. epidermidis — один из наиболее часто выделяемых микроорганизмов у пациентов, находящихся на стационарном лечении. Из-за его повсеместного присутствия на коже, нередко обнаружение этой бактерии в образцах может расцениваться как контаминация (загрязнение образца), а не истинная инфекция.
Тем не менее, S. epidermidis ассоциируется с большим числом внутрибольничных инфекций благодаря его способности образовывать биоплёнки на медицинских устройствах (внутрисосудистых катетерах), обширных ранах, протезах и искусственных сердечных клапанах.
Основные симптомы: Симптомы инфекции, вызванной Staphylococcus epidermidis, как правило, проявляются только при попадании бактерии в кровоток. Это может включать высокую температуру, головную боль, общее недомогание, одышку или затруднённое дыхание, а также снижение артериального давления.
Как проводится лечение: Лечение инфекции S. epidermidis варьируется в зависимости от типа инфекции и характеристик выделенного микроорганизма. Если инфекция связана с колонизацией медицинских устройств, может потребоваться их замена для устранения источника бактерий. При подтверждённой инфекции врач также может назначить антибиотики, такие как Ванкомицин и Рифампицин.
3. Staphylococcus saprophyticus (Сапрофитный стафилококк)
Staphylococcus saprophyticus, или S. saprophyticus, может естественным образом присутствовать на коже и в генитальной области, не вызывая при этом никаких симптомов.
Однако при нарушении баланса микрофлоры в области гениталий S. saprophyticus может стать причиной инфекций мочевыводящих путей, особенно у женщин. Это объясняется способностью данной бактерии эффективно прикрепляться к клеткам мочевыделительной системы женщин репродуктивного возраста.
Основные симптомы: Симптомы инфекции, вызванной S. saprophyticus, идентичны признакам других инфекций мочевыводящих путей: боль и затруднение при мочеиспускании, мутная моча, ощущение неполного опорожнения мочевого пузыря и длительная субфебрильная температура.
Как проводится лечение: Лечение инфекции S. saprophyticus осуществляется с применением антибиотиков, например, Триметоприма. Однако антибиотики должны назначаться врачом только при наличии выраженных симптомов, так как их необоснованное применение может способствовать развитию устойчивых штаммов бактерий.